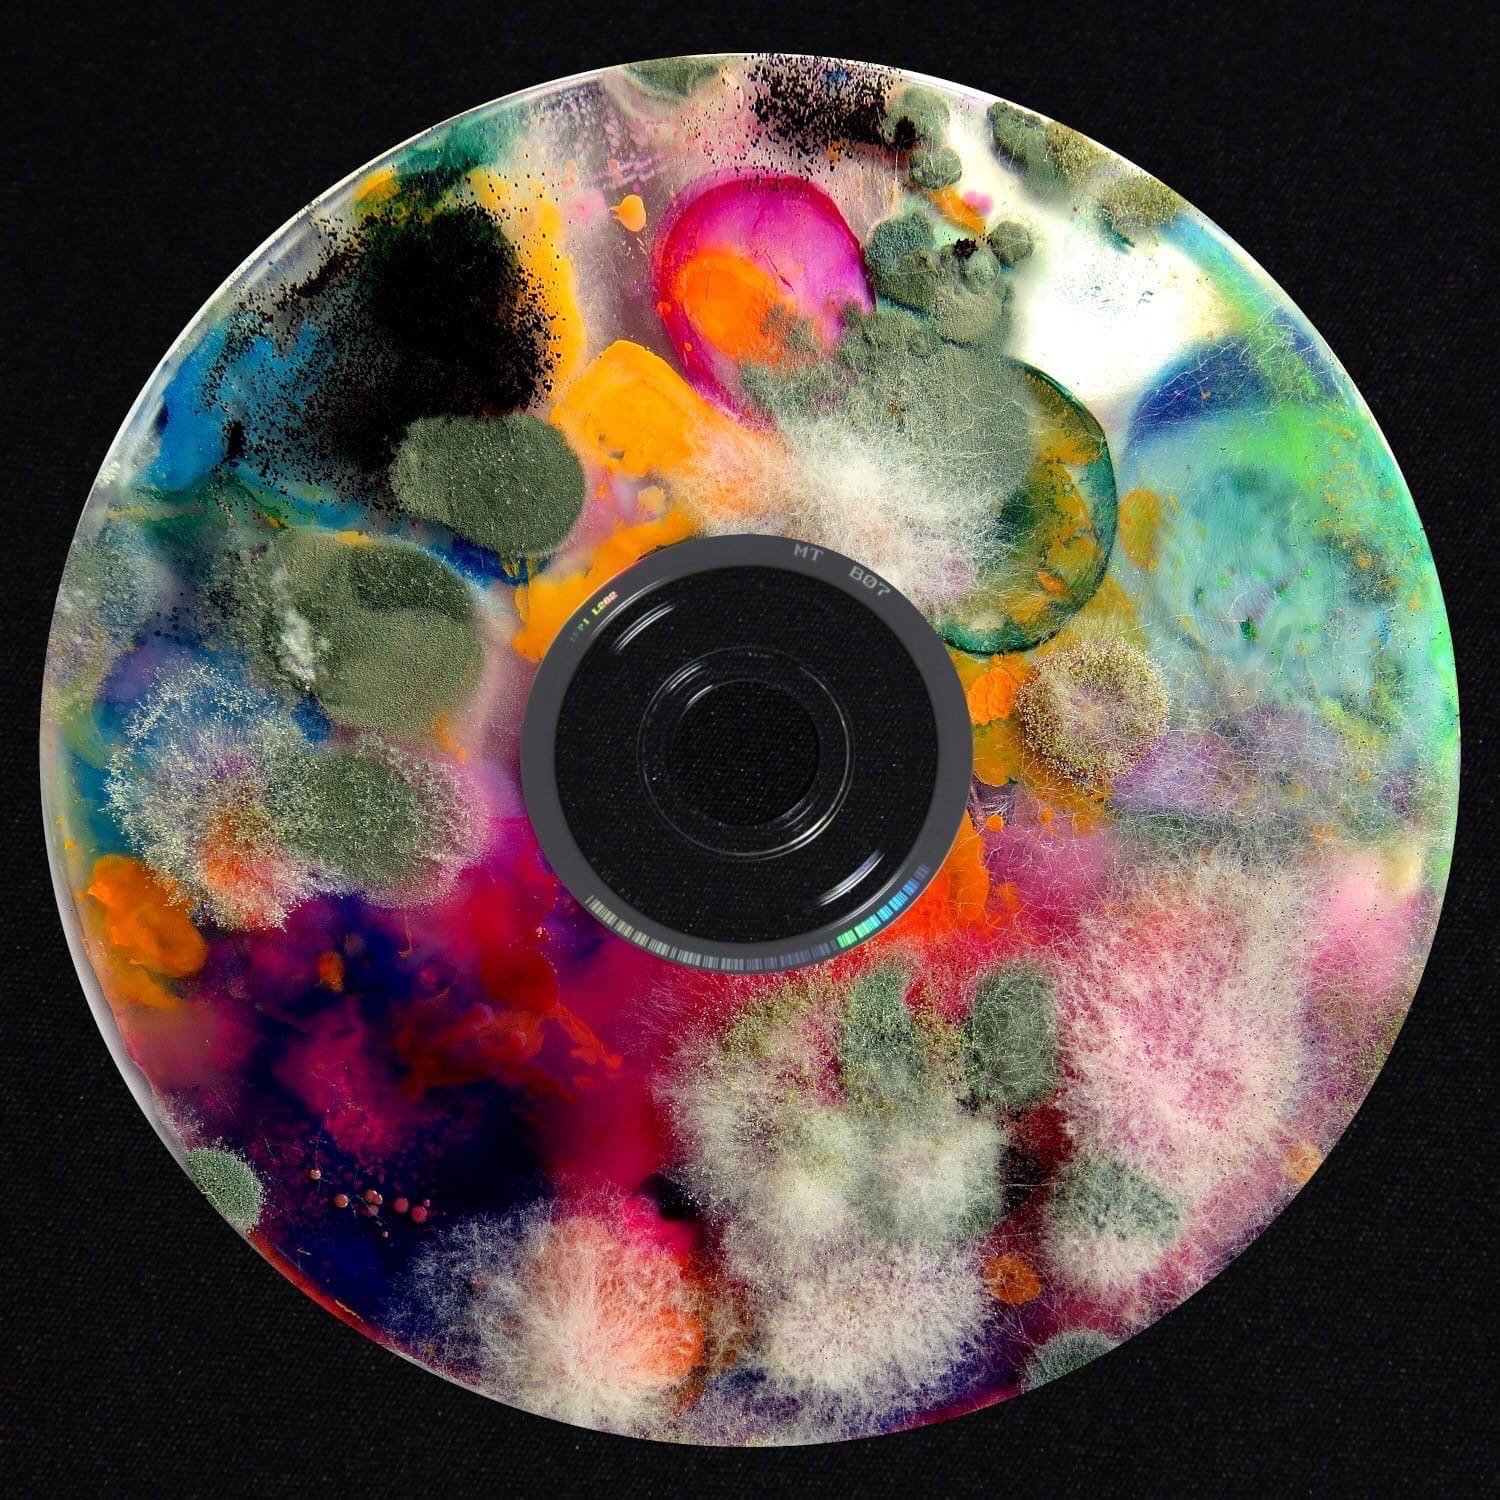

Boulevard depo feat jeembo
Очный смешанный формат
Древняя таверна
Как проверить слово животных
Такого большого я еще не видела
Полиция новости про зарплату
Enfield bullet 350
Прикол поклон
Охтинский колледж большевиков 38
Движение я тоже
Трикотажные кофты выкройки
Погода в николо александровское левокумском районе
Беспроводная камера для авто
Передние поворотники на электровелосипед
Boulevard depo feat jeembo 108 фото